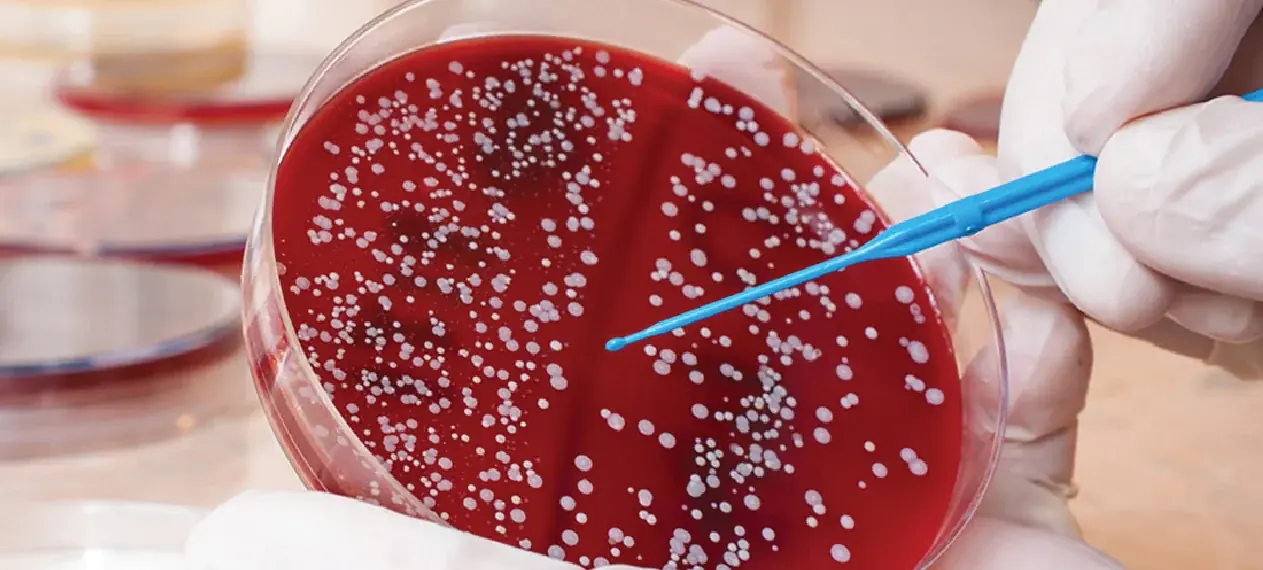

Warning: 10 Overlooked Symptoms That Could Signal Bloo.d Can.cer

Blood cancer is one of the most dangerous diseases, yet many people tend to overlook its early warning signs because they are often mistaken for common health problems. Early detection can significantly increase the chances of successful treatment and improve quality of life. In this article, we will outline 10 common signs of blood cancer that patients frequently ignore. Don’t take them lightly—listen to your body to protect your health in time!
1. Overview of Blood Cancer
Blood cancer (also known as hematologic cancer) refers to a group of malignant diseases that affect the production and function of blood cells. These cells are primarily produced in the bone marrow and play a crucial role in the body’s immune system. When blood cancer develops, the production and functioning of blood cells are disrupted, leading to serious health complications.
There are three main types of blood cancer:
-
Leukemia: A condition in which the bone marrow produces an excessive number of abnormal white blood cells. This weakens the immune system and interferes with the growth of healthy blood cells.
-
Lymphoma: This cancer affects the lymphatic system—a vital part of the immune system—causing uncontrolled proliferation of abnormal lymphocytes.
-
Multiple Myeloma: A cancer of plasma cells in the bone marrow, leading to their abnormal accumulation and impairing the production of antibodies needed for immunity.
Diagnosis and screening for blood cancer often include blood tests, bone marrow biopsy, and imaging techniques. Treatment depends on the type of cancer, the stage of the disease, and the overall health of the patient. Options may include chemotherapy, radiation therapy, immunotherapy, and bone marrow transplantation.
Awareness of blood cancer symptoms, along with regular cancer screening, plays an essential role in early detection and effective treatment.
2. Warning: 10 Common Signs of Blood Cancer
Recognizing early warning signs of blood cancer can greatly improve diagnosis and treatment outcomes. Below are some of the most common symptoms:
2.1. Persistent Fatigue
Unexplained tiredness that does not improve with adequate rest may indicate a decrease in red blood cells caused by blood cancer.
2.2. Frequent Fever and Infections
A weakened immune system due to abnormal white blood cells makes the body more susceptible to infections and recurrent fevers. This is a common but often overlooked sign of blood cancer.
2.3. Unexplained Weight Loss
Sudden weight loss without changes in diet or physical activity could be a warning sign.
2.4. Night Sweats
Excessive sweating at night, often soaking clothes and bed sheets, is a frequent symptom in blood cancer patients.
2.5. Easy Bruising or Bleeding
A drop in platelet count impairs blood clotting, making bruising, gum bleeding, or nosebleeds more common.
2.6. Bone or Joint Pain
Often mistaken for bone or joint disorders, pain in these areas can result from cancer cell buildup in the bone marrow.
2.7. Swollen Lymph Nodes
Lymph nodes in the neck, armpits, or groin may swell without pain due to the spread of cancer cells.
2.8. Pale or Yellowish Skin
Anemia caused by reduced red blood cells can lead to pale skin, while in some cases, red blood cell destruction may cause jaundice.
2.9. Shortness of Breath
Reduced oxygen levels due to fewer red blood cells may cause difficulty breathing, especially during physical activity.
2.10. Skin Rash or Red Spots
Low platelet levels can cause small red spots on the skin, known as petechiae.
If you or a loved one experience these symptoms—especially if they persist or worsen—consult a doctor for timely examination and diagnosis. Early detection is key to effective treatment and better quality of life.
3. Risk Factors for Blood Cancer
The exact cause of blood cancer remains unclear. However, several risk factors have been identified, including:
-
Genetics: A family history of blood cancer may increase the risk.
-
Exposure to toxic chemicals: Frequent contact with substances like benzene can heighten the risk.
-
Radiation exposure: High levels of radiation, such as from nuclear accidents, may contribute to disease development.
-
Weakened immune system: Individuals with compromised immunity or those on immunosuppressive drugs face higher risks.
4. Why Are Blood Cancer Symptoms Often Misdiagnosed?
Blood cancer—including leukemia, lymphoma, and multiple myeloma—often manifests through nonspecific symptoms that resemble other common illnesses. Main reasons include:
4.1. Overlapping Symptoms
Signs like fatigue, fever, weight loss, and night sweats are also seen in flu, infections, or stress.
4.2. Subtle Early Manifestations
At early stages, symptoms are mild and nonspecific, leading patients to dismiss them.
4.3. Wide Range of Symptoms
Since blood cancer affects multiple body systems, it presents a variety of symptoms, complicating accurate diagnosis.
4.4. Limited Awareness
Many people lack awareness of blood cancer symptoms, delaying timely medical consultation.
Thus, raising awareness and undergoing regular cancer screening is vital for early detection and treatment.
5. How to Detect Blood Cancer Early
Early detection of blood cancer is crucial for improving treatment outcomes and survival rates. Methods include:
5.1. Complete Blood Count (CBC)
This test evaluates the number and quality of red blood cells, white blood cells, and platelets. Abnormal results may indicate possible blood cancer.
5.2. Bone Marrow Biopsy
If CBC results suggest abnormalities, a bone marrow biopsy can confirm the presence and type of blood cancer.
5.3. Monitoring Unusual Symptoms
Keep track of persistent symptoms like unexplained fatigue, fever, weight loss, night sweats, easy bruising or bleeding, bone or joint pain, and swollen lymph nodes. If these occur, seek medical advice promptly.
5.4. Family History and Risk Factors
Individuals with a family history of blood cancer, exposure to harmful chemicals or radiation, or weakened immunity should undergo screening.
6. Conclusion: Early Detection Improves Prognosis
Early detection of blood cancer through screening and awareness of abnormal symptoms can significantly enhance treatment outcomes. Take charge of your health by undergoing recommended tests.
At FV Hospital, we offer advanced cancer screening services to help detect blood cancer and other types of cancer at the earliest possible stage.
News in the same category


Health experts warn that one popular habit with boiled eggs could raise your risk of artery blockage, but countless people still follow it every day

Not Everyone Should Eat Onions: Here’s Who Needs to Be Careful

If you have these 6 signs on your feet, you should see a doctor soon because your health is having serious problems

Off The Record One Month Before A Heart Attack, Your Body Will Warn You Of These 7 Signs

Four Drinks You Should NEVER Have in the Morning—Even If You Wake Up Extremely Thirsty: They Damage the Li.ver, Harm the Kid.neys, and “Steal” Your Lifespan

4 Finger Changes You Shouldn’t Ignore — Possible Signs of Lung Cancer

Middle-Aged People, Stop Doing These 7 Things-Even in the Cold Winter-Before It's Too Late!

How Sleeping on Your Left Side Supports Brain, Digestive, and Lymphatic Health

Your feet are a "bl.o.od sugar meter" Beware of diabetes if you frequent experience these 5 strange symptoms

Causes and symptoms of an umb:ilical hernia

7 indicators that your kidneys are functioning well - check

12 Benefits You’ll See After Eating Banana and Avocado Every Morning

Swollen Lymph Nodes in the Ne.ck - Here's When You Need to Worry

5 foods you should never keep overnight, if left over, throw it away

Early Warning Signs That C.a.ncer Is Growing In Your Body

The liver is an important detoxification and metabolic organ of the body.

People Sho:cked to Learn Reason Public Toilet Doors Don’t Touch The Floor

You shouldn't ignore these signs
News Post

Head and Neck Cancer: Risk Factors, Symptoms, and Prevention Tips

Health experts warn that one popular habit with boiled eggs could raise your risk of artery blockage, but countless people still follow it every day

Not Everyone Should Eat Onions: Here’s Who Needs to Be Careful

Mopping with Plain Water Is Pointless: Add This One Thing and Your Floor Will Shine Like a Mirror All Week!

Stir-Fried Squid with Green Onions & Chili

If you have these 6 signs on your feet, you should see a doctor soon because your health is having serious problems

Beef Rolls with Asparagus (Soy Garlic Glaze)

Off The Record One Month Before A Heart Attack, Your Body Will Warn You Of These 7 Signs

Vietnamese Spicy Pork Ear Salad

Four Drinks You Should NEVER Have in the Morning—Even If You Wake Up Extremely Thirsty: They Damage the Li.ver, Harm the Kid.neys, and “Steal” Your Lifespan

Thai Shrimp Glass Noodle Salad (Yum Woon Sen)

Crispy Roast Duck with Soy Glaze

Baked King Crab with Garlic Butter & Cream Sauce

Spicy Garlic Chili Crab

Pan-Fried Fish Cakes with Spicy Red Sauce

Pumpkin Crunch Parfaits

Calling all sweet potato fans!

4 Finger Changes You Shouldn’t Ignore — Possible Signs of Lung Cancer
